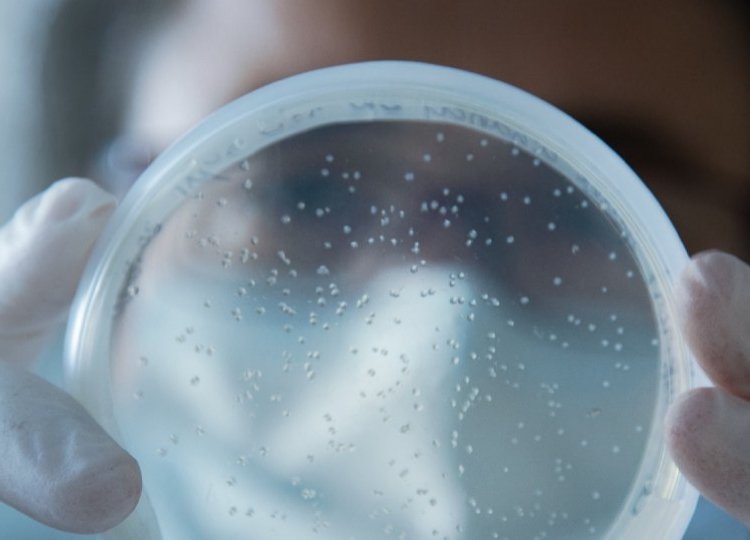

O Instituto de Medicina Molecular – João Lobo Antunes (iMM) lançou um novo projeto, o iMM-Laço Hub.
Em outubro de 2021, mês internacional da luta contra o cancro da mama, surge assim o iMM-Laço Hub, uma nova iniciativa que é constituída por duas partes que se complementam e que não vivem uma sem a outra: um laboratório focado na investigação em cancro da mama metastático e uma equipa que tem como função dedicar-se à relação da ciência com a sociedade civil.
“Esta estrutura multidisciplinar que junta médicos e cientistas com um objetivo comum – compreender as interações celulares e do microambiente tumoral no cancro da mama. É este conhecimento que permitirá desenhar estratégias terapêuticas eficazes para o cancro da mama metastático”, explica Maria Manuel Mota, diretora executiva do iMM.
Este projeto surge na sequência do Fundo iMM-Laço, criado em 2015, quando Lynne Archibald, Presidente da Associação Laço, delega ao iMM a tarefa de manter viva a luta contra o cancro da mama.
O arranque desta iniciativa é marcado pela doação ao iMM de uma parte da herança da bailarina Ana Lázaro, que será aplicado na investigação do cancro da mama.
Em Portugal, cerca de 7 mil pessoas recebem todos os anos o diagnóstico de cancro da mama e mais de 1 500 perdem a vida para esta doença.
“Os avanços alcançados ao longos dos últimos anos, permitiram um rastreio efetivo onde são detetados tumores na mama cada vez mais cedo. Os tratamentos de quimioterapia e radioterapia e as cirurgias de remoção do tumor, são cada vez mais eficazes e permitem aos doentes alcançar uma taxa de sobrevivência cada vez maior. No entanto, ainda há várias questões para as quais não há resposta e onde a ciência, o conhecimento e a investigação científica são as melhores armas que podemos dispor”, referem os responsáveis do iMM-Laço Hub.

Equipa do iMM-Laço Hub
A equipa do iMM-Laço Hub disposta a investigar e avançar nas respostas ao cancro da mama é liderada pelo Consultor Científico e investigador principal do iMM, Sérgio Dias.
Na área científica, o Breast Cancer Lab vai ser coordenado pela investigadora Karine Serre e terá o suporte do Laboratório de Oncologia, liderado por Luis Costa, diretor do Serviço de Oncologia do Hospital de Santa Maria e investigador principal do iMM.
Será também apoiado pelo Laboratório de Biologia Computacional, liderado por Nuno Morais, investigador principal do iMM e o Biobanco do Centro Académico e de Medicina de Lisboa (CAML).
A apoiar o lado científico estará a equipa de fundraising, outro dos pontos fundamentais para o iMM-Laço Hub, que apostará na sensibilização da sociedade para a doença.
A equipa de fundrising da iniciativa permitirá associar “os pedidos de fundos ao número de pessoas que todos os anos se veem impactadas por uma doença grave e incapacitante que muitas vezes resulta em fatalidade. O objetivo é envolver a sociedade civil e também prestar homenagem na forma de recolha de fundos”, referem os promotores da iniciativa.

“Este projeto compromete-se também a honrar a história de Ana Lázaro, mulher, bailarina e filantropa que, ao deixar parte da sua herança ao iMM como apoio à ciência, é um exemplo de como todos podemos contribuir para e estar cada vez mais envolvidos com a ciência e investigação em Portugal”, salienta ainda Maria Manuel Mota.
O iMM-Laço Hub com imagem e assinatura da autoria da agência 9 foi apresentado esta sexta-feira, 1 de outubro, em Lisboa.
Quem era Ana Lázaro
Mulher, bailarina, coreógrafa, professora de dança, filantropa, Ana Lázaro nasceu em 1933, filha do pintor português Bonifácio Lázaro Lozano.
Nascida em Portugal, mas também com nacionalidade espanhola, Ana Lázaro vive os primeiros anos em Lisboa, mudando-se com a família para Madrid onde prossegue a sua carreira na dança. Primeiro como bailarina e mais tarde como coreógrafa e professora de dança, tendo encabeçado a primeira cátedra de Dança Clássica na Real Escuela Superior de Arte Dramático y Danza.
Ana Lázaro teve um papel importante na divulgação da dança clássica, onde teve programas de aulas de ballet na televisão espanhola e até mesmo um documentário sobre a história da dança.
Pela sua escola passaram nomes importantes da dança espanhola como Nazaret Panadero ou Virginia Valero, diretora do Conservatório Superior de Dança de Madrid.
Morreu em Madrid, neste ano de 2021, aos 81 anos de idade.
Movida por um profundo sentido de solidariedade, e acreditando que cada um pode deixar uma marca importante no mundo, destinou parte da sua herança à ciência, com uma doação ao iMM.